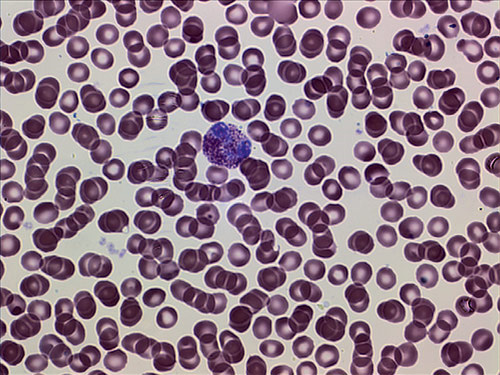
Мазок крови. Окраска азур-эозином по Романовскому. Увеличение 1000×. На фотографии: эозинофил на фоне эритроцитов
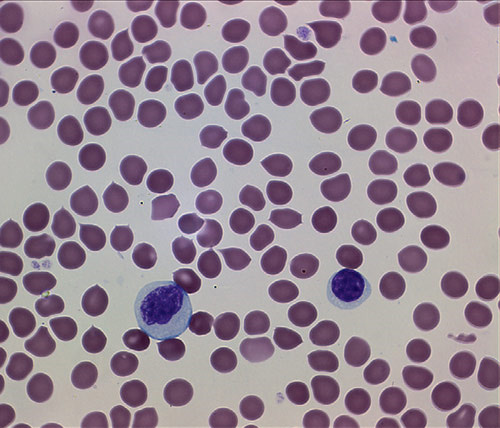
Мазок крови. Окраска азур-эозином по Романовскому. Увеличение 1000×. На фотографии: слева — моноцит, справа — лимфоцит

Станислав Яблоков,
Ярославский государственный университет им. П. Г. Демидова
«Наука и жизнь» №2, 2014
Вот уже два года, как я наблюдаю за микромиром у себя дома, и год, как снимаю его на фотокамеру. За это время собственными глазами увидел, как выглядят клетки крови, чешуйки, опадающие с крыльев бабочек, как бьётся сердце улитки. Конечно, многое можно было бы узнать из учебников, видеолекций и тематических сайтов. Но при этом не было бы ощущения присутствия, близости к тому, что не видно невооружённым глазом. Что это не просто слова из книжки, а личный опыт. Опыт, который сегодня доступен каждому.
Театр начинается с вешалки, а микросъёмка с покупки оборудования, и прежде всего — микроскопа. Одна из основных его характеристик — набор доступных увеличений, которые определяются произведением увеличений окуляра и объектива.

Не всякий биологический образец хорош для просмотра при большом увеличении. Связано это с тем, что чем больше увеличение оптической системы, тем меньше глубина резкости. Следовательно, изображение неровных поверхностей препарата частично будет размыто. Поэтому важно иметь набор объективов и окуляров, позволяющий вести наблюдения с увеличением от 10–20 до 900–1000×. Иногда бывает оправданно добиться увеличения 1500× (окуляр 15 и объектив 100×). Большее увеличение бессмысленно, так как более мелкие детали не позволяет видеть волновая природа света.

Лист клевера. Увеличение 100×. Некоторые клетки содержат тёмно-красный пигмент
Следующий немаловажный момент — тип окуляра. «Сколькими глазами» вы хотите рассматривать изображение? Обычно выделяют монокулярную, бинокулярную и тринокулярную его разновидности. В случае монокуляра придётся щуриться, утомляя глаз при длительном наблюдении. В бинокуляр смотрят обоими глазами (не следует путать его со стереомикроскопом, дающим объёмное изображение). Для фото- и видеосъёмки микрообъектов понадобится «третий глаз» — насадка для установки аппаратуры. Многие производители выпускают специальные камеры для своих моделей микроскопов, но можно использовать и обычный фотоаппарат, купив к нему переходник.

Лист земляники. Увеличение 40×
Наблюдение при больших увеличениях требует хорошего освещения в силу небольшой апертуры объективов. Световой пучок от осветителя, преобразованный в оптическом устройстве — конденсоре, освещает препарат. В зависимости от характера освещения существует несколько способов наблюдения, самые распространённые из которых — методы светлого и тёмного поля. В первом, самом простом, знакомом многим ещё со школы, препарат освещают равномерно снизу. При этом через оптически прозрачные детали препарата свет распространяется в объектив, а в непрозрачных он поглощается и рассеивается. На белом фоне получается тёмное изображение, отсюда и название метода. С тёмнопольным конденсором всё иначе. Световой пучок, выходящий из него, имеет форму конуса, лучи в объектив не попадают, а рассеиваются на непрозрачном препарате, в том числе и в направлении объектива. В итоге на тёмном фоне виден светлый объект. Такой метод наблюдения хорош для исследования прозрачных малоконтрастных объектов. Поэтому, если вы планируете расширить набор методов наблюдения, стоит выбирать модели микроскопов, в которых предусмотрена установка дополнительного оборудования: конденсора тёмного поля, тёмнопольной диафрагмы, устройств фазового контраста, поляризаторов и т. п.
Оптические системы не идеальны: прохождение света через них сопряжено с искажениями изображения — аберрациями. Поэтому объективы и окуляры стараются изготавливать так, чтобы эти аберрации максимально устранить. Всё это сказывается на их конечной стоимости. Из соображений цены и качества имеет смысл покупать планахроматические объективы для профессиональных исследований. Сильные объективы (с увеличением, например, 100×) имеют числовую апертуру больше 1 при использовании иммерсии, масла с высоким показателем преломления, раствора глицерина (для УФ-области) или просто воды. Поэтому, если кроме «сухих» объективов вы берёте ещё и иммерсионные, стоит заранее позаботиться об иммерсионной жидкости. Её показатель преломления обязательно должен соответствовать конкретному объективу.
Иногда следует обратить внимание на устройство предметного столика и рукояток для управления им. Стоит выбрать и тип осветителя, которым может быть как обычная лампа накаливания, так и светодиод, который ярче и греется меньше. Микроскопы тоже имеют индивидуальные особенности. Каждая дополнительная опция — это добавка в цене, поэтому выбор модели и комплектации остаётся за потребителем.
Сегодня нередко покупают недорогие микроскопы для детей, монокуляры с небольшим набором объективов и скромными параметрами. Они могут послужить хорошей отправной точкой не только для исследования микромира, но и для ознакомления с основными принципами работы микроскопа. После этого ребёнку уже стоит купить более серьёзное устройство.
Можно купить далеко не дешёвые наборы готовых препаратов, но тогда не таким ярким будет ощущение личного участия в исследовании, да и наскучат они рано или поздно. Поэтому следует позаботиться и об объектах для наблюдения, и о доступных средствах для подготовки препаратов.
Наблюдение в проходящем свете предполагает, что исследуемый объект достаточно тонок. Даже кожура ягоды или фрукта слишком толста, поэтому в микроскопии исследуют срезы. В домашних условиях их делают обычными бритвенными лезвиями. Чтобы не смять кожуру, её помещают между кусочками пробки или заливают парафином. При определённой сноровке можно достигнуть толщины среза в несколько клеточных слоёв, а в идеале следует работать с моноклеточным слоем ткани — несколько слоёв клеток создают нечёткое сумбурное изображение.

Крыло жучка бибиониды. Увеличение 400×
Исследуемый препарат помещают на предметное стекло и в случае необходимости закрывают покровным. Купить стёкла можно в магазине медицинской техники. Если препарат плохо прилегает к стеклу, его фиксируют, слегка смачивая водой, иммерсионным маслом или глицерином. Не всякий препарат сразу открывает свою структуру, иногда ему нужно «помочь», подкрасив его форменные элементы: ядра, цитоплазму, органеллы. Неплохими красителями служат йод и «зелёнка». Йод достаточно универсальный краситель, им можно окрашивать широкий спектр биологических препаратов.
При выезде на природу следует запастись баночками для набора воды из ближайшего водоёма и маленькими пакетиками для листьев, высохших остатков насекомых и т. п.
Микроскоп приобретён, инструменты закуплены — пора начинать. И начать следует с самого доступного — например, кожуры репчатого лука. Тонкая сама по себе, подкрашенная йодом, она обнаруживает в своём строении чётко различимые клеточные ядра. Этот опыт, хорошо знакомый со школы, и стоит провести первым. Луковую кожуру нужно залить йодом на 10–15 минут, после чего промыть под струёй воды.

Кожица лука. Увеличение 1000×. Окраска йодом. На фотографии видно клеточное ядро

Кожица лука. Увеличение 1000×. Окраска азур-эозином. На фотографии в ядре заметно ядрышко
Кроме того, йод можно использовать для окраски картофеля. Срез необходимо сделать как можно более тонким. Буквально 5–10 минут его пребывания в йоде проявят пласты крахмала, который окрасится в синий цвет.

Картофель. Синие пятна — зёрна крахмала. Увеличение 100×. Окраска йодом
На балконах часто скапливается большое количество трупиков летающих насекомых. Не торопитесь от них избавляться: они могут послужить ценным материалом для исследования. Как видно из фотографий, вы обнаружите, что на крыльях насекомых есть волоски, которые защищают их от намокания. Большое поверхностное натяжение воды не позволяет капле «провалиться» сквозь волоски и коснуться крыла.

Плёнка на спине таракана. Увеличение 400×
Если вы когда-нибудь задевали крыло бабочки или моли, то, наверное, замечали, что с неё слетает какая-то «пыль». На снимках отчётливо видно, что это не пыль, а чешуйки с крыльев. Они имеют разную форму и довольно легко отрываются.

Чешуйки с крыльев моли. Увеличение 400×
Кроме того, с помощью микроскопа можно изучить строение конечностей насекомых и пауков, рассмотреть, например, хитиновые плёнки на спине таракана. И при должном увеличении убедиться, что такие плёнки состоят из плотно прилегающих (возможно, сросшихся) чешуек.

Крыло бабочки боярышницы. Увеличение 100×
Не менее интересный объект для наблюдения — кожура ягод и фруктов. Однако либо её клеточное строение может быть неразличимым, либо её толщина не позволит добиться чёткого изображения. Так или иначе, придётся сделать немало попыток, прежде чем получится хороший препарат: перебрать разные сорта винограда, чтобы найти тот, у которого красящие вещества кожуры имели бы интересную форму, или сделать несколько срезов кожицы сливы, добиваясь моноклеточного слоя. В любом случае вознаграждение за проделанную работу будет достойным.

Кожура сливы. Увеличение 1000×
Ещё более доступны для исследования трава, водоросли, листья. Но, несмотря на повсеместную распространённость, выбрать и приготовить из них хороший препарат бывает непросто. Самое интересное в зелени — это, пожалуй, хлоропласты. Поэтому срез должен быть исключительно тонким.

Хлоропласты в клетках травы. Увеличение 1000×
Приемлемой толщиной нередко обладают зелёные водоросли, встречающиеся в любых открытых водоёмах. Там же можно найти плавучие водоросли и микроскопических водных обитателей — мальков улитки, дафний, амёб, циклопов и туфелек. Маленький детёныш улитки, оптически прозрачный, позволяет разглядеть у себя биение сердца.

Хлоропласты в клетках водоросли. Увеличение 1000×
После изучения простых и доступных препаратов захочется усложнить технику наблюдения и расширить класс исследуемых объектов. Для этого понадобится и специальная литература, и специализированные средства, свои для каждого типа объектов, но всё-таки обладающие некоторой универсальностью. Например, метод окраски по Граму, когда разные виды бактерий начинают различаться по цвету, можно применить и для других, не бактериальных, клеток. Близок к нему и метод окраски мазков крови по Романовскому. В продаже имеется как уже готовый жидкий краситель, так и порошок, состоящий из его компонентов — азура и эозина. Их можно купить в специализированных магазинах либо заказать в интернете. Если раздобыть краситель не удастся, можно попросить у лаборанта, делающего вам анализ крови в поликлинике, стёклышко с окрашенным её мазком.
Мазок крови. Окраска азур-эозином по Романовскому. Увеличение 1000×. На фотографии: эозинофил на фоне эритроцитов
Продолжая тему исследования крови, следует упомянуть камеру Горяева — устройство для подсчёта количества клеток крови и оценки их размеров. Методы исследования крови и других жидкостей с помощью камеры Горяева описаны в специальной литературе.
Мазок крови. Окраска азур-эозином по Романовскому. Увеличение 1000×. На фотографии: слева — моноцит, справа — лимфоцит
***
В современном мире, где разнообразные технические средства и устройства находятся в шаговой доступности, каждый сам решает, на что ему потратить деньги. Это может быть дорогостоящий ноутбук или телевизор с запредельным размером диагонали. Находятся и те, кто отводит свой взор от экранов и направляет его далеко в космос, приобретая телескоп. Микроскопия может стать интересным хобби, а для кого-то даже и искусством, средством самовыражения. Глядя в окуляр микроскопа, проникают глубоко внутрь той природы, часть которой мы сами.
Фото автора.
Словарик к статье
Апертура — действующее отверстие оптической системы, определяемое размерами зеркал, линз, диафрагм и других деталей. Угол α между крайними лучами конического светового пучка называется угловой апертурой. Числовая апертура А = n sin(α/2), где n — показатель преломления среды, в которой находится объект наблюдения. Разрешающая способность прибора пропорциональна А, освещённость изображения А2. Чтобы увеличить апертуру, применяют иммерсию.
Иммерсия — прозрачная жидкость с показателем преломления n > 1. В неё погружают препарат и объектив микроскопа, увеличивая его апертуру и тем самым повышая разрешающую способность.
Планахроматический объектив — объектив с исправленной хроматической аберрацией, который создаёт плоское изображение по всему полю. Обычные ахроматы и апохроматы (аберрации исправлены для двух и для трёх цветов соответственно) дают криволинейное поле, которое исправить невозможно.
Фазовый контраст — метод микроскопических исследований, основанный на изменении фазы световой волны, прошедшей сквозь прозрачный препарат. Фаза колебания не видна простым глазом, поэтому специальная оптика — конденсор и объектив — превращает разность фаз в негативное или позитивное изображение.
Моноциты — одна из форм белых клеток крови.
Хлоропласты — зелёные органеллы растительных клеток, отвечающие за фотосинтез.
Эозинофилы — клетки крови, играющие защитную роль при аллергических реакциях.
«Наука и жизнь» о микросъёмке:
Микроскоп «Аналит» — 1987, №1.
Ошанин С. Л. С микроскопом у пруда. — 1988, №8.
Ошанин С. Л. Невидимая миру жизнь. — 1989, №6.
Милославский В. Ю. Домашняя микрофотография. — 1998, №1.
Мологина Н. Фотоохота: макро и микро. — 2007, №4.
Детёныш улитки. Увеличение 40×